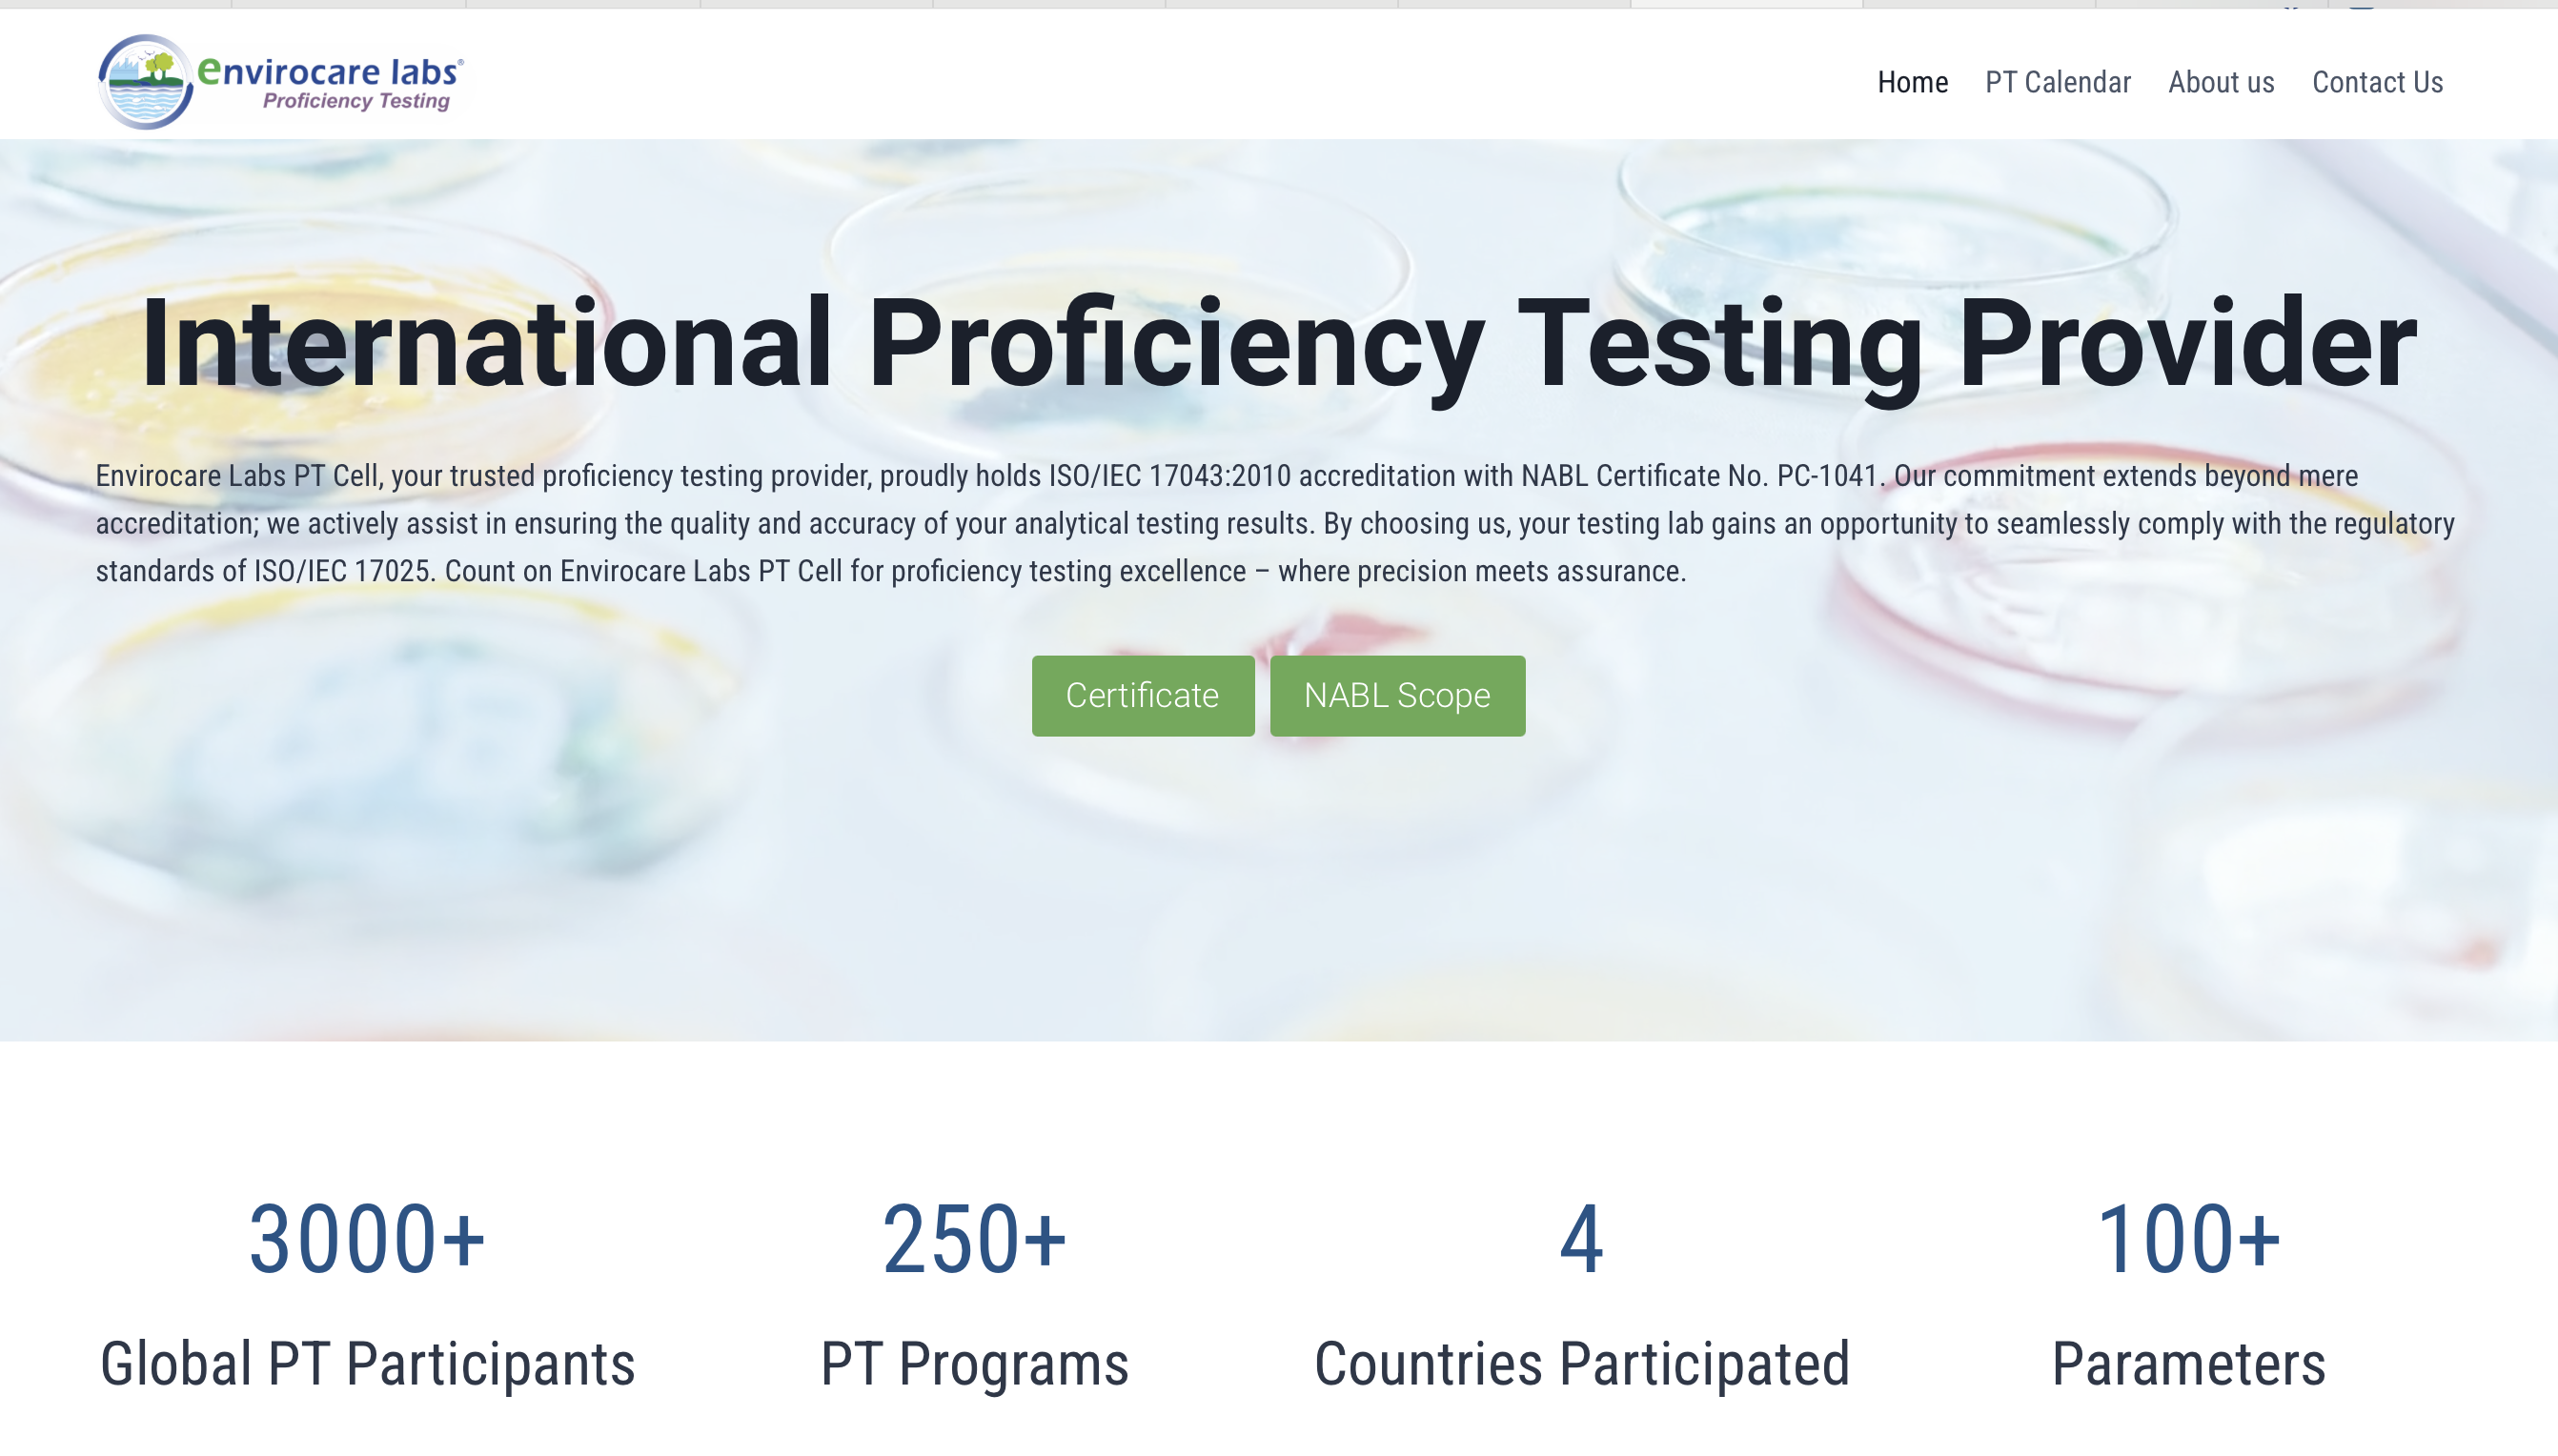

Stop Losing Business to Poor Website Design
Get a professional website that works as hard as you do. We handle everything – design, development, and engaging content.
Website Solutions for Every Need
From simple landing pages to complex e-commerce stores, we build the perfect website for your business goals.
Success Stories That Drive Action
From Vulnerable to Virtually Impenetrable

The Challenge: Hindustan Colas (a joint venture between HPCL and Colas SA France) operated an outdated website, exposing its digital assets to security risks and failing to reflect its industry leadership.
Our Solution: We engineered a fortress-like WordPress website with:
The Impact:
Envirocare Labs: The 3-Year Wait Ends in 20 Days

The Challenge: After 3 years of broken promises and wasted resources with multiple agencies, this leading laboratory testing company had almost given up on having a professional website. That’s where we stepped in.
Our Solution:Delivered a comprehensive digital presence in record time:
The Breakthrough:
People Powered Solutions:Zero to Digital Hero

The Challenge: A leading recruitment firm was losing opportunities daily, buried under manual processes and invisible online. The lack of digital infrastructure stunted their growth.
Our Solution:Built a powerhouse recruitment platform featuring:
The Impact:
Proficiency Testing Cell: Local to Global Leader
The Challenge: Limited by a basic website, this PT service provider was struggling to reach international markets and automate their program delivery.
Our Game-Changing Solution:Developed a custom e-commerce platform featuring:
The Global Impact:
Home Square Property: From Unknown to Unstoppable
The Challenge: A real estate startup with zero market presence needed to generate qualified leads in a highly competitive market – fast.
Our Solution:Crafted a high-converting digital presence:
TThe Results That Speak Volumes:
Ready to Write Your Success Story?
Your business deserves more than just a website. Let’s create your digital success story together.

Discovery Call
30-minute discussion to understand your business goals and requirements
Design & Content
We create your design and write engaging content simultaneously


Development
Transform designs into a fully functional website
Launch
Final testing and website launch

Your Customers Are Online. Are You?
While you’re reading this, your competitors are capturing your potential customers.
